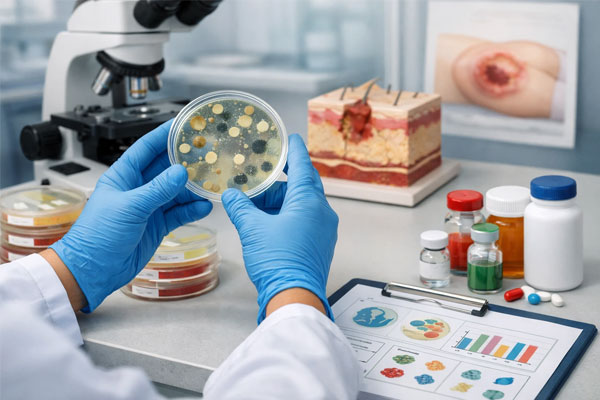

بهترین آنتیبیوتیک برای زخم بستر | انتخاب داروی مناسب زخم عفونی
در این مقاله، نشانههای کلیدی عفونت زخم بستر و راهکارهای اثباتشده درمان، به شکلی تحلیلی و کاربردی بررسی گردیده است. انتخاب صحیح آنتیبیوتیک خوراکی و تزریقی، نقش کشت میکروبی در بهبود قطعی و ضرورت پرهیز از مصرف خودسرانه دارو به روشنی تشریح شده است.
روشهای نوین پانسمان، پمادهای مؤثر و اصول دبریدمان برای بیماران زخم بستر معرفی و ارزیابی گردیدهاند. همچنین اقدامات مکمل مانند کاهش فشار، تغذیه مناسب و جدول قیمت خدمات درمانی بهروز ارائه شده است. خواننده با پیروی از توصیههای مقاله میتواند جهش قابل توجهی در درمان و پیشگیری از بازگشت عفونت تجربه کند.
فهرست عناوین

تعرفه درمانی زخم های فشاری
همزمان با افزایش نیاز بیماران ناتوان و سالمند، خدمات درمان زخم بستر و فشاری در منزل به یکی از پرتقاضاترین شاخههای مراقبت تبدیل شده است.
این خدمات نسبت به نوع زخم، وسعت آسیب و تکنولوژی مصرفی، طیفی وسیع از قیمتها را دربرمیگیرد. هزینه هر جلسه درمان در سال ۱۴۰۴، بسته به ساده یا مزمن بودن زخم و نوع پانسمان انتخابی، اختلاف قابل توجهی دارد.
اطلاع از تعرفهها کمک میکند بیماران تصمیم دقیقتر و واقعبینانه داشته باشند. جدول زیر راهنمای میانگین قیمت انواع خدمات تخصصی زخم در مراکز معتبر کشور است. هر رقم بابت یک جلسه یا خدمت تخصصی در منزل محاسبه شده است.
جدول قیمت ها
| نوع خدمت | حداقل قیمت (تومان) | حداکثر قیمت (تومان) |
|---|---|---|
| ویزیت و ارزیابی اولیه | ۴۰۰,۰۰۰ | ۹۰۰,۰۰۰ |
| پانسمان ساده | ۷۰۰,۰۰۰ | ۱,۰۰۰,۰۰۰ |
| پانسمان پیشرفته (نوین) | ۱,۲۰۰,۰۰۰ | ۲,۰۰۰,۰۰۰ |
| درمان زخم سطحی تا متوسط | ۸۵۰,۰۰۰ | ۱,۵۰۰,۰۰۰ |
| درمان زخم عمیق/مزمن (درجه ۳ و ۴) | ۱,۵۰۰,۰۰۰ | ۵,۰۰۰,۰۰۰ |
| دبریدمان تخصصی | ۱,۰۰۰,۰۰۰ | ۲,۵۰۰,۰۰۰ |

ویژه : تعویض پانسمان در منزل
نشانههای عفونت زخم های بستر چیست؟
عفونت زخم بستر اغلب با تغییرات مشهود در محل زخم آشکار میشود و شناسایی سریع آن، اهمیت بالایی برای موفقیت درمان دارد.
قرمزی اطراف زخم، تورم و افزایش گرمای پوست، ممکن است اولین نشانههای هشداری باشند که باید جدی گرفته شوند. ترشحات بدبو یا تغییر رنگ زخم معمولاً خبر از حضور باکتریهای مهاجم میدهند و نیاز به پیگیری حرفهای دارند.
در برخی موارد، درد شدید یا حساسیت غیرمنتظره به لمس میتواند نشانه پیشرفت عفونت به لایههای عمیقتر باشد. تب، بیحالی و حتی نهایتاً سردی اطراف زخم بستر، از نشانههای جدی گسترش عفونت به کل بدن محسوب میشود.
شناسایی و واکنش به این علائم به موقع، احتمال موفقیت آنتیبیوتیک یا دبریدمان زخم را افزایش میدهد. افراد دارای بیماریهای زمینهای یا ضعف ایمنی باید نسبت به کوچکترین نشانههای عفونت، حساس و پیگیر باشند و در صورت مشاهده، فوراً به پزشک مراجعه نمایند.
علائم هشداردهنده پیشروی عفونت
مهمترین علامت هشداردهنده عفونت زخم بستر، قرمزی غیرعادی و گسترش یافته در پوست اطراف محل آسیب است. تورم ناگهانی یا افزایش حجم زخم، میتواند نشانهای از التهاب داخلی و فعالیت میکروبی زیاد باشد.
ترشح زرد، سبز یا سفید رنگ، همراه با بوی نامطبوع، اغلب به دلیل حضور باکتریهای عفونتزا مشاهده میشود. بروز درد جدید یا تشدید درد زخم که با استراحت نیز فروکش نمیکند، باید جدی گرفته شود.
بالا رفتن تدریجی دمای بدن، لرز یا بیحالی غیرمعمول، زنگ خطری برای ورود میکروبها به خون هستند. تضعیف وضعیت عمومی یا احساس سرگیجه و ضعف شدید، نیازمند ارزیابی فوری توسط پزشک میباشد.
نادیده گرفتن این نشانهها میتواند منجر به وخامت وضعیت بیمار و گسترش عفونت شود؛ پس باید هر نشانه را به موقع گزارش کنید.
چگونه تشخیص باکتری زخم انجام میشود؟
تشخیص نوع باکتری زخم بستر با معاینه دقیق و استفاده از ابزارهای تخصصی پزشکی انجام میشود. نخست پزشک ظاهر زخم، رنگ، بوی ترشحات، و میزان التهاب بافت را بررسی میکند تا احتمال نوع باکتری را ارزیابی کند.
نمونهای از ترشحات یا بافت زخم با سوآب استریل گرفته و به آزمایشگاه ارسال میشود. در آزمایشگاه، کشت میکروبی برای شناسایی گونههای باکتریایی و شدت عفونت صورت میگیرد. بررسی حساسیت میکروب نسبت به انواع آنتیبیوتیک نیز اجرا میشود تا داروی مؤثر انتخاب گردد.
اگر زخم شدید یا عمقی باشد، تستهای پیشرفتهتری مانند آزمایش خون برای رد سپسیس ممکن است لازم شود. تشخیص صحیح نوع باکتری، کلید انتخاب آنتیبیوتیک مناسب و افزایش موفقیت درمان زخم بستر را تضمین میکند.
نقش کشت میکروبی در انتخاب دارو
کشت میکروبی زخم بستر نقش کلیدی در تعیین بهترین آنتیبیوتیک برای درمان دارد و جلوی مصرف بیرویه داروها را میگیرد. نتیجه کشت مشخص میسازد کدام گروه باکتری (مثلاً گرم مثبت، گرم منفی یا بیهوازی) عامل عفونت است.
این اطلاعات به پزشک اجازه میدهد آنتیبیوتیک خاصی را تجویز کند که دقیقاً هدف باکتری عامل بیماری را قرار دهد. اگر زخم به داروهای معمولی پاسخ ندهد، کشت کمک میکند داروهای تخصصیتر مانند وانکومایسین یا لاینزولید برای میکروبهای مقاوم انتخاب شود.
نتیجه کشت میتواند از خوددرمانی و خطاهای دارویی جلوگیری کند و احتمال درمان قطعی را افزایش دهد. در بیمارانی با سابقه بستری طولانی یا زخمهای مزمن، نقش کشت میکروبی در کاهش عوارض درمانی و هزینهها برجستهتر میشود.
تمام بیماران باید بدانند مصرف آنتیبیوتیک بدون تست کشت، شانس درمان دائمی زخم را کم میکند و عوارض بیشتری به دنبال خواهد داشت.
ویژه : درمان زخم های جراحی
بهترین آنتیبیوتیک برای زخم عمیق بستر
انتخاب آنتیبیوتیک خوراکی برای درمان عفونت زخم بستر باید بر اساس نوع باکتری، شدت عارضه و وضعیت عمومی بیمار باشد. بیشتر اوقات، پزشکان با توجه به نتیجه کشت ترشحات زخم تصمیم میگیرند کدام دارو را تجویز کنند.
داروهای خوراکی برای زخمهای سطحی، عفونت خفیف یا شرایطی که بیمار بستری نیست، کاربرد بیشتری دارند. مصرف صحیح آنتیبیوتیک خوراکی کمک میکند درمان زخم سریعتر و بدون عوارض اضافه صورت گیرد.
انتخاب نادرست یا استفاده خودسرانه از این داروها میتواند به مقاومت باکتریایی و بدتر شدن وضعیت بیمار منجر شود.
آنتیبیوتیک خوراکی باید هماهنگ با مراقبتهای عمومی، تعویض منظم پانسمان و رعایت رژیم غذایی مناسب استفاده شود. مشاوره با پزشک و توجه به هشدارها و نشانههای عفونت، ضامن اثرگذاری بهتر درمان خوراکی میشود.
معرفی رایجترین داروهای خوراکی
رایجترین آنتیبیوتیکهای خوراکی برای زخم بستر سفالکسین، آموکسیسیلین-کلاوولانات، کلیندامایسین و مترونیدازول هستند. سفالکسین بیشتر برای عفونتهای خفیف و سطحی باکتریهای گرم مثبت تجویز میشود و تحمل خوبی دارد.
آموکسیسیلین-کلاوولانات طیف وسیعتری را پوشش داده و در زخمهایی با التهاب بیشتر یا ترشح بدبو به کار میرود. کلیندامایسین معمولا زمانی مصرف میشود که نیاز به کنترل عفونتهای عمقی یا باکتریهای بیهوازی وجود دارد.
مترونیدازول در زخمهایی با بوی تعفن یا وقتی بافت مرده زیاد است، انتخاب فعال درمانگران است. سیپروفلوکساسین نیز برای عفونتهای مقاوم یا مزمن مصرف خوراکی دارد اما تحت نظر پزشک باید استفاده شود.
آنتیبیوتیکهای خوراکی تنها وقتی مؤثرند که عامل عفونت مشخص شده باشد و مصرف آنها بیهدف توصیه نمیشود.
تفاوت درمان سفالکسین و آموکسیسیلین
سفالکسین به عنوان دارویی پرکاربرد و نسبتاً کمعارضه، اغلب نخستین انتخاب برای زخمهای سطحی و عفونتهای محدود است.
مصرف سفالکسین معمولاً در بیماران سالم با عفونت ملایم یا زخم تازه مؤثر است و تحمل دارویی خوبی دارد. آموکسیسیلین کلاوولانات با طیف وسیعتر، در شرایطی که عفونت پیچیدهتر یا ترشح بدبو و التهاب بافت اطراف دیده میشود استفاده میشود.
این دارو در کنترل رشد باکتریهای گرم منفی و بیهوازی نسبتاً قویتر عمل میکند و برای زخمهای مزمن مناسبتر است. مدت زمان و دوز هر دو دارو باید با نظر پزشک و پس از بررسی پاسخ به درمان تنظیم شود.
در برخی بیماران عارضه گوارشی با آموکسیسیلین ممکن است بروز کند که باید اطلاع داده شود. انتخاب بین دو دارو به شدت و نوع عفونت، نتیجه کشت و وضعیت سابقه بیماری فرد بستگی دارد. هرگز دو دارو را همزمان بدون توصیه پزشک مصرف نکنید تا جلوی مقاومت باکتریایی گرفته شود.
چه زمانی مترونیدازول یا کلیندامایسین لازم است؟
مترونیدازول و کلیندامایسین زمانی لازم میشوند که زخم بستر با علائم بیهوازی یا عفونتهای عمقی، بوی بد و بافت مرده همراه باشد.
اگر نمونه آزمایشگاه نشان دهد عفونت به علت رشد باکتریهای بیهوازی یا گرم منفی ایجاد شده، استفاده از مترونیدازول اولویت دارد.
کلیندامایسین هم برای عفونتهای مقاوم یا مواردی که سفالکسین و آموکسیسیلین مؤثر نیستند، تجویز میشود. این دو دارو معمولاً برای بیماران دیابتی، زخمهای مزمن یا مواردی که روند بهبودی کند است، کاربرد دارند.
ترکیب مترونیدازول با کلیندامایسین یا سایر آنتیبیوتیکها در عفونتهای چندباکتریایی زیر نظر پزشک انجام میشود. مصرف این داروها بیهدف یا بدون بررسی نوع باکتری توصیه نمیشود تا از عوارض و مقاومت دارویی پیشگیری گردد. پاسخ به درمان باید حتماً توسط پزشک پایش و در صورت لزوم تغییر دارو طبق وضعیت بیمار انجام شود.

ویژه : درمان زخم های سوختگی
قویترین آنتیبیوتیک تزریقی زخم های بستر
در مراحل پیشرفته یا شدید زخم بستر که علائم عفونت گسترده و عمومی دیده میشود، درمان خوراکی دیگر کافی نیست و باید به تزریق آنتیبیوتیک قوی رو آورد.
انتخاب داروی تزریقی، بر مبنای شدت علائم بالینی، نتیجه کشت میکروبی و پاسخ به درمانهای قبلی صورت میگیرد. داروهایی مانند سفتریاکسون و پیپراسیلین-تازوباکتام، خط اول تزریقی برای کنترل سریع عفونت گسترده هستند.
در عفونتهای مقاوم یا زمانی که بیمار قبلاً به داروهای رایج پاسخ نداده، وانکومایسین یا لاینزولید وارد چرخه درمان میشوند.
تجویز فرم تزریقی معمولاً با نظارت مستقیم تیم پزشکی آغاز میشود تا عوارض و واکنشهای ناگهانی کنترل گردد. گاهی برای بیماران بستری، ترکیب چند داروی تزریقی بهترین شانس زندهماندن یا بهبود بافت را پدید میآورد.
انتقال بیمار به مرکز درمانی مجهز برای انجام این درمانها، به خصوص در سالمندان و بیماران دچار ضعف بدنی، اهمیت دوچندان دارد.
نقش سفتریاکسون و پیپراسیلین در زخمهای شدید
سفتریاکسون یکی از قویترین آنتیبیوتیکهای تزریقی محسوب میشود که در درمان بسیاری از عفونتهای شدید زخم بستر کاربرد گسترده دارد.
این دارو طیف وسیعی از باکتریهای شایع در زخم، بهویژه انواع گرم منفی و مثبت را پوشش میدهد. پیپراسیلین-تازوباکتام نیز یک داروی ترکیبی و بسیار مؤثر است که علاوه بر اثرگذاری بر انواع باکتریهای رایج، علیه میکروبهای مقاوم و بیهوازی هم فعالیت بالایی دارد.
استفاده از این دو دارو معمولاً در مواقعی توصیه میشود که بیمار نشانههایی از گسترش عفونت، ترشح حجیم و یا تب شدید دارد.
سرعت اثرگذاری آنها برای مهار تکثیر باکتری و پیشگیری از عوارض جدی مانند سپسیس یا تخریب بافت حیاتی است. انتخاب هرکدام، بسته به نتیجه کشت، وضعیت کلی بدن بیمار و وجود حساسیت دارویی انجام میشود.
معمولاً میزان و مدت زمان مصرف توسط متخصص عفونی یا پزشک مراقبت ویژه تنظیم خواهد شد. رعایت پروتکل تزریق صحیح و پایش نشانههای بهبودی یا عوارض جانبی ضروری است.
درمان مقاومتی با وانکومایسین و لاینزولید
زمانی که عوامل عفونت زخم بستر نسبت به سایر آنتیبیوتیکها مقاوم شوند یا کشت زخم نشانگر حضور میکروبهای خاصی نظیر MRSA باشد، داروهای اختصاصی مانند وانکومایسین و لاینزولید وارد برنامه درمان میشوند.
وانکومایسین یک آنتیبیوتیک تزریقی بسیار قوی است که به صورت ویژه برای میکروبهای مقاوم گرم مثبت به کار میرود.
لاینزولید هم از معدود آنتیبیوتیکهایی است که هم به شکل خوراکی و هم تزریقی، قادر به کنترل عفونتهای چندمقاومتی است و اغلب زمانی تجویز میشود که همه گزینههای قبلی شکست خوردهاند.
این دو دارو، به دلیل عوارض جانبی و پیچیدگی مصرف، معمولاً صرفاً تحت نظارت متخصص عفونی و در محیط بیمارستان استفاده میشوند. مانیتورینگ میزان دارو در بدن و بررسی عوارض کلیوی یا خونی برای پیشگیری از خطرات احتمالی الزامی است.
بنابراین تجویز آنها نزد هر بیماری تنها زمانی انجام میشود که عفونت به مرحله خطرناک یا تهدیدکننده حیات رسیده باشد. درمان با این داروها اغلب نیاز به بستری طولانیمدت، پایش آزمایشگاهی و همزمان مراقبت چندرشتهای دارد.
کدام بیمار نیاز به تزریق بیمارستانی دارد؟
بیمارانی که با وجود مصرف داروهای خوراکی، نشانههای عفونت پیشرفته در زخم بستر مانند تب بالا، علائم سپسیس، یا ترشح شدید ادامهدار دارند، نیاز فوری به درمان تزریقی پیدا میکنند.
همچنین افرادی که دچار ضعف سیستم ایمنی، سن بالا، دیابت کنترلنشده، مشکلات کلیوی یا ابتلای مزمن به بیماریهای دیگر هستند، نباید درمان خوراکی را ادامه دهند و بررسی بستری شدن ضرورت پیدا میکند.
اگر زخم به لایههای عمیقتر گسترش یافته، بافت سیاه (نکروز) یا بوی بد و عفونت چندمیکروبی دیده میشود، تزریق بیمارستانی بهترین شانس کنترل عفونت است.
گاهی نیز وجود افت فشار خون، تنگی نفس یا تغییر سطح هوشیاری، نشانه آغاز عوارض سیستمی بوده و با دیرکرد در تزریق قویترین آنتیبیوتیکها، جان بیمار به خطر میافتد.
بیماران دچار زخمهای درجه ۳ و ۴ به ویژه با پانسمان مکرر عفونی، از اصلیترین گروههایی هستند که باید تزریق مراقبتی دریافت کنند.
انتخاب نهایی همیشه باید توسط تیم پزشکی با ارزیابی مستند از وضعیت همزمان خون، کلیه و عملکرد قلب تعیین شود. مراقبت اورژانسی و نظارت بیمارستانی، تضمینکننده اثربخشی و امنیت درمان در این بیماران خواهد بود.

ویژه : درمان زخم های دیابتی
۴ گام طلایی درمان آنتیبیوتیکی زخم فشاری
درمان موفق عفونت زخم بستر تنها وابسته به آنتیبیوتیک نیست؛ بلکه ترکیبی از مراقبتهای تکمیلی و اقدامات تخصصی نوین میتواند شانس بهبودی قطعی را افزایش دهد. تجارب بیمارستانها و کلینیکهای معتبر نشان میدهد که دبریدمان علمی، پانسمانهای نسل جدید، استفاده بجا از پمادهای آنتیبیوتیکی و اصلاح سبک زندگی بیمار نقش تعیینکنندهای دارند. اگر به تازگی با زخم بستر یا عوارض ناشی از غفلت در مراقبت مواجه شدهاید، این راهنمای گامبهگام برای شماست. هر مرحله زیر با توصیههای تخصصی و کاملاً عملی طراحی شده تا خانواده، پرستار یا حتی خود بیمار بتواند اصول مراقبت موثر و پیشگیری از بازگشت عفونت را پیاده کند.
گام اول: دبریدمان تخصصی و پانسمان نوین
برداشتن بافت مرده یا آلوده باید توسط پزشک و با تکنیکهای پیشرفته مانند آنزیمی، اولتراسوند یا لیزر انجام گیرد. این کار، محیط زخم را برای ترمیم بافت سالم و کاهش خطر عفونت مهیا میکند. انتخاب پانسمان بیواکتیو (هیدروژل، آلژینات، کامفیل) بر اساس عمق و شرایط زخم نقش مهمی در جذب ترشحات و حفظ رطوبت دارد. برنامه منظم تعویض پانسمان و رعایت دستور پزشک، به موفقیت درمان کمک میکند. هرگز بدون مشورت تخصصی یا آموزش لازم اقدام نکنید. کیفیت دبریدمان و پانسمان، ستون اول درمان پایدار است.
گام دوم: استفاده هوشمندانه از پمادهای آنتیبیوتیک
برای کنترل عفونت سطحی و تسریع بهبود، انتخاب پماد مناسب اهمیت بالایی دارد. تتراسایکلین، موپیروسین، سیلور سولفادیازین یا فوسیدیک اسید هرکدام برای باکتریهای خاص موثرند. مصرف آنها باید فقط زیر نظر پزشک یا پرستار مجرب باشد تا از عوارض جانبی یا تداخلهای دارویی جلوگیری شود. استفاده همزمان چند پماد بدون تجویز تخصصی ممنوع است، چون مقاومت میکروبی یا تأخیر بهبودی ایجاد میکند. رعایت اصول ضدعفونی و زمان مصرف پماد، یعنی حداکثر نتیجه با کمترین خطر.
گام سوم: کاهش مستمر فشار روی محل زخم
درمان زخم بستر تنها با دارو موثر نیست؛ باید به تغییر وضعیت بدن بیمار هر ۲–۳ ساعت توجه شود تا فشار ناخواسته به محل زخم نیاید. استفاده از تشک مواج، بالشتهای تخصصی و حتی آموزش حرکتدادن اصولی بیمار، مانع گسترش آسیب و عفونت میشود. کنار این اقدامات، چک روزانه محلهای پرخطر برای جلوگیری از نقاط جدید زخم توصیه میشود. مراقبت مکانیکی یعنی ایمنی بدن و موفقیت داروها تضمین میگردد.
گام چهارم: تغذیه کامل و آبرسانی هدفمند
یک رژیم غذایی سرشار از پروتئین، ویتامین C و روی، نیروی دفاع بدن را تقویت و فرآیند ترمیم را سرعت میبخشد. کمبودهای تغذیهای موجب ضعف سیستم ایمنی و طولانیشدن دوره درمان خواهد شد. نوشیدن آب کافی، دوری از خوراک ناسالم و همکاری با پزشک یا کارشناس تغذیه برای تنظیم رژیم نقش حیاتی دارد. در بیماران زخم بستر، تغذیه درمانی شرط بهبود مطلوب و پیشگیری از بازگشت آسیب است.

ویژه : درمان زخم های عفونی
مقاله مرتبط با درمان زخم بستر با آنتی بیوتیک :
Evidence for antibiotics and antiseptics in healing pressure ulcers is surprisingly weak.
Many small and short trials show no clear advantage over non‑antimicrobial dressings.
In some studies, ordinary dressings without antibiotics actually performed better.
Experts say better, larger studies are needed before routine antibiotic use can be justified.
ترجمه فارسی
شواهد مربوط به تأثیر آنتیبیوتیکها و آنتیسپتیکها در ترمیم زخم بستر، برخلاف تصور، چندان قوی نیست.
بسیاری از مطالعات کوچک و کوتاهمدت، برتری مشخصی نسبت به پانسمانهای بدون ماده ضدمیکروبی نشان نمیدهند.
در برخی تحقیقات حتی پانسمانهای معمولیِ بدون آنتیبیوتیک بهتر عمل کردهاند.
متخصصان تأکید میکنند تا زمانی که مطالعات بزرگتر و باکیفیتتر انجام نشود، تجویز روتین آنتیبیوتیک برای زخم بستر قابل توجیه نیست.
منبع: (PMC6486293)
سوالات رایج
نشانههای اولیه عفونت زخم های بستر چیست؟
اگر اطراف زخم قرمز، گرم یا متورم شد و ترشحات بوی بد یا تغییر رنگ پیدا کرد، احتمال عفونت بالاست. درد جدید یا افزایش حساسیت محل زخم، یا تب و بیحالی، نشانههایی هستند که به پیگیری پزشکی فوری نیاز دارند تا از پیشرفت عفونت جلوگیری شود.
چرا باید قبل از تجویز آنتیبیوتیک، کشت میکروبی انجام دهیم؟
کشت میکروبی کمک میکند نوع دقیق باکتری عامل زخم شناسایی شود و آنتیبیوتیک موثر تجویز گردد. این کار از مصرف بیهدف دارو و مقاومت بعدی جلوگیری میکند و شانس درمان کامل زخم را بیشتر میکند. در زخمهای مزمن، این روند ضروری است.
تفاوت سفالکسین و آموکسیسیلین در ترمیم زخم عمیق بستر چیست؟
سفالکسین بیشتر برای زخمهای خفیف و سطحی باکتریهای گرم مثبت استفاده میشود و عوارض کمتری دارد. آموکسیسیلین-کلاوولانات طیف وسیعتری دارد و معمولا در زخمهای عمیقتر، مزمن یا با ترشح بدبو کاربرد دارد. انتخاب بین آنها باید با نظر پزشک باشد.
چه زمانی لازم است از آنتیبیوتیک تزریقی استفاده شود؟
در صورت تب بالا، بوی شدید، ترشح زیاد یا آسیب عمقی، آنتیبیوتیکهای تزریقی مثل سفتریاکسون یا پیپراسیلین لازم میشوند. همچنین بیماران با ایمنی پایین نیاز به درمان بیمارستانی دارند. انتخاب داروی تزریقی بسته به شدت عفونت باید توسط پزشک باشد.
کدام پمادهای موضعی برای این زخم ها مفید هستند؟
پمادهای ضدعفونیکننده مثل تتراسایکلین، سیلور سولفادیازین یا فوسیدیک اسید معمولاً زیر نظر پزشک استفاده میشوند. هریک برای عفونت خاص یا مرحله معین زخم مناسب است. از مصرف همزمان چند پماد و خوددرمانی پرهیز کنید تا روند بهبود مختل نشود.
دبریدمان زخم فشاری چیست و چرا اهمیت دارد؟
دبریدمان یعنی برداشتن بافت مرده یا آلوده زخم با روشهای تخصصی. این کار به ترمیم سریعتر و جلوگیری از گسترش عفونت کمک میکند. دبریدمان باید فقط توسط پزشک یا تیم درمان ماهر انجام شود تا آسیبی به بافت سالم نرسد و عفونت کنترل گردد.
برای پیشگیری از زخم های بستر چه کارهایی باید انجام داد؟
تغییر وضعیت مرتب بیمار روی تخت یا ویلچر، استفاده از تشک مواج و بالشت مناسب، چک کردن منظم پوست و تغذیه سالم با پروتئین و ویتامین کافی، مهمترین اقدامات پیشگیرانه است. این کارها باعث کاهش فشار و افزایش جریان خون در پوست شده و زخم تازه ایجاد نمیشود.
منابع :
(cochranelibrary)
(researchgate)
(ncbi.nlm.nih)
(tidsskriftet)
